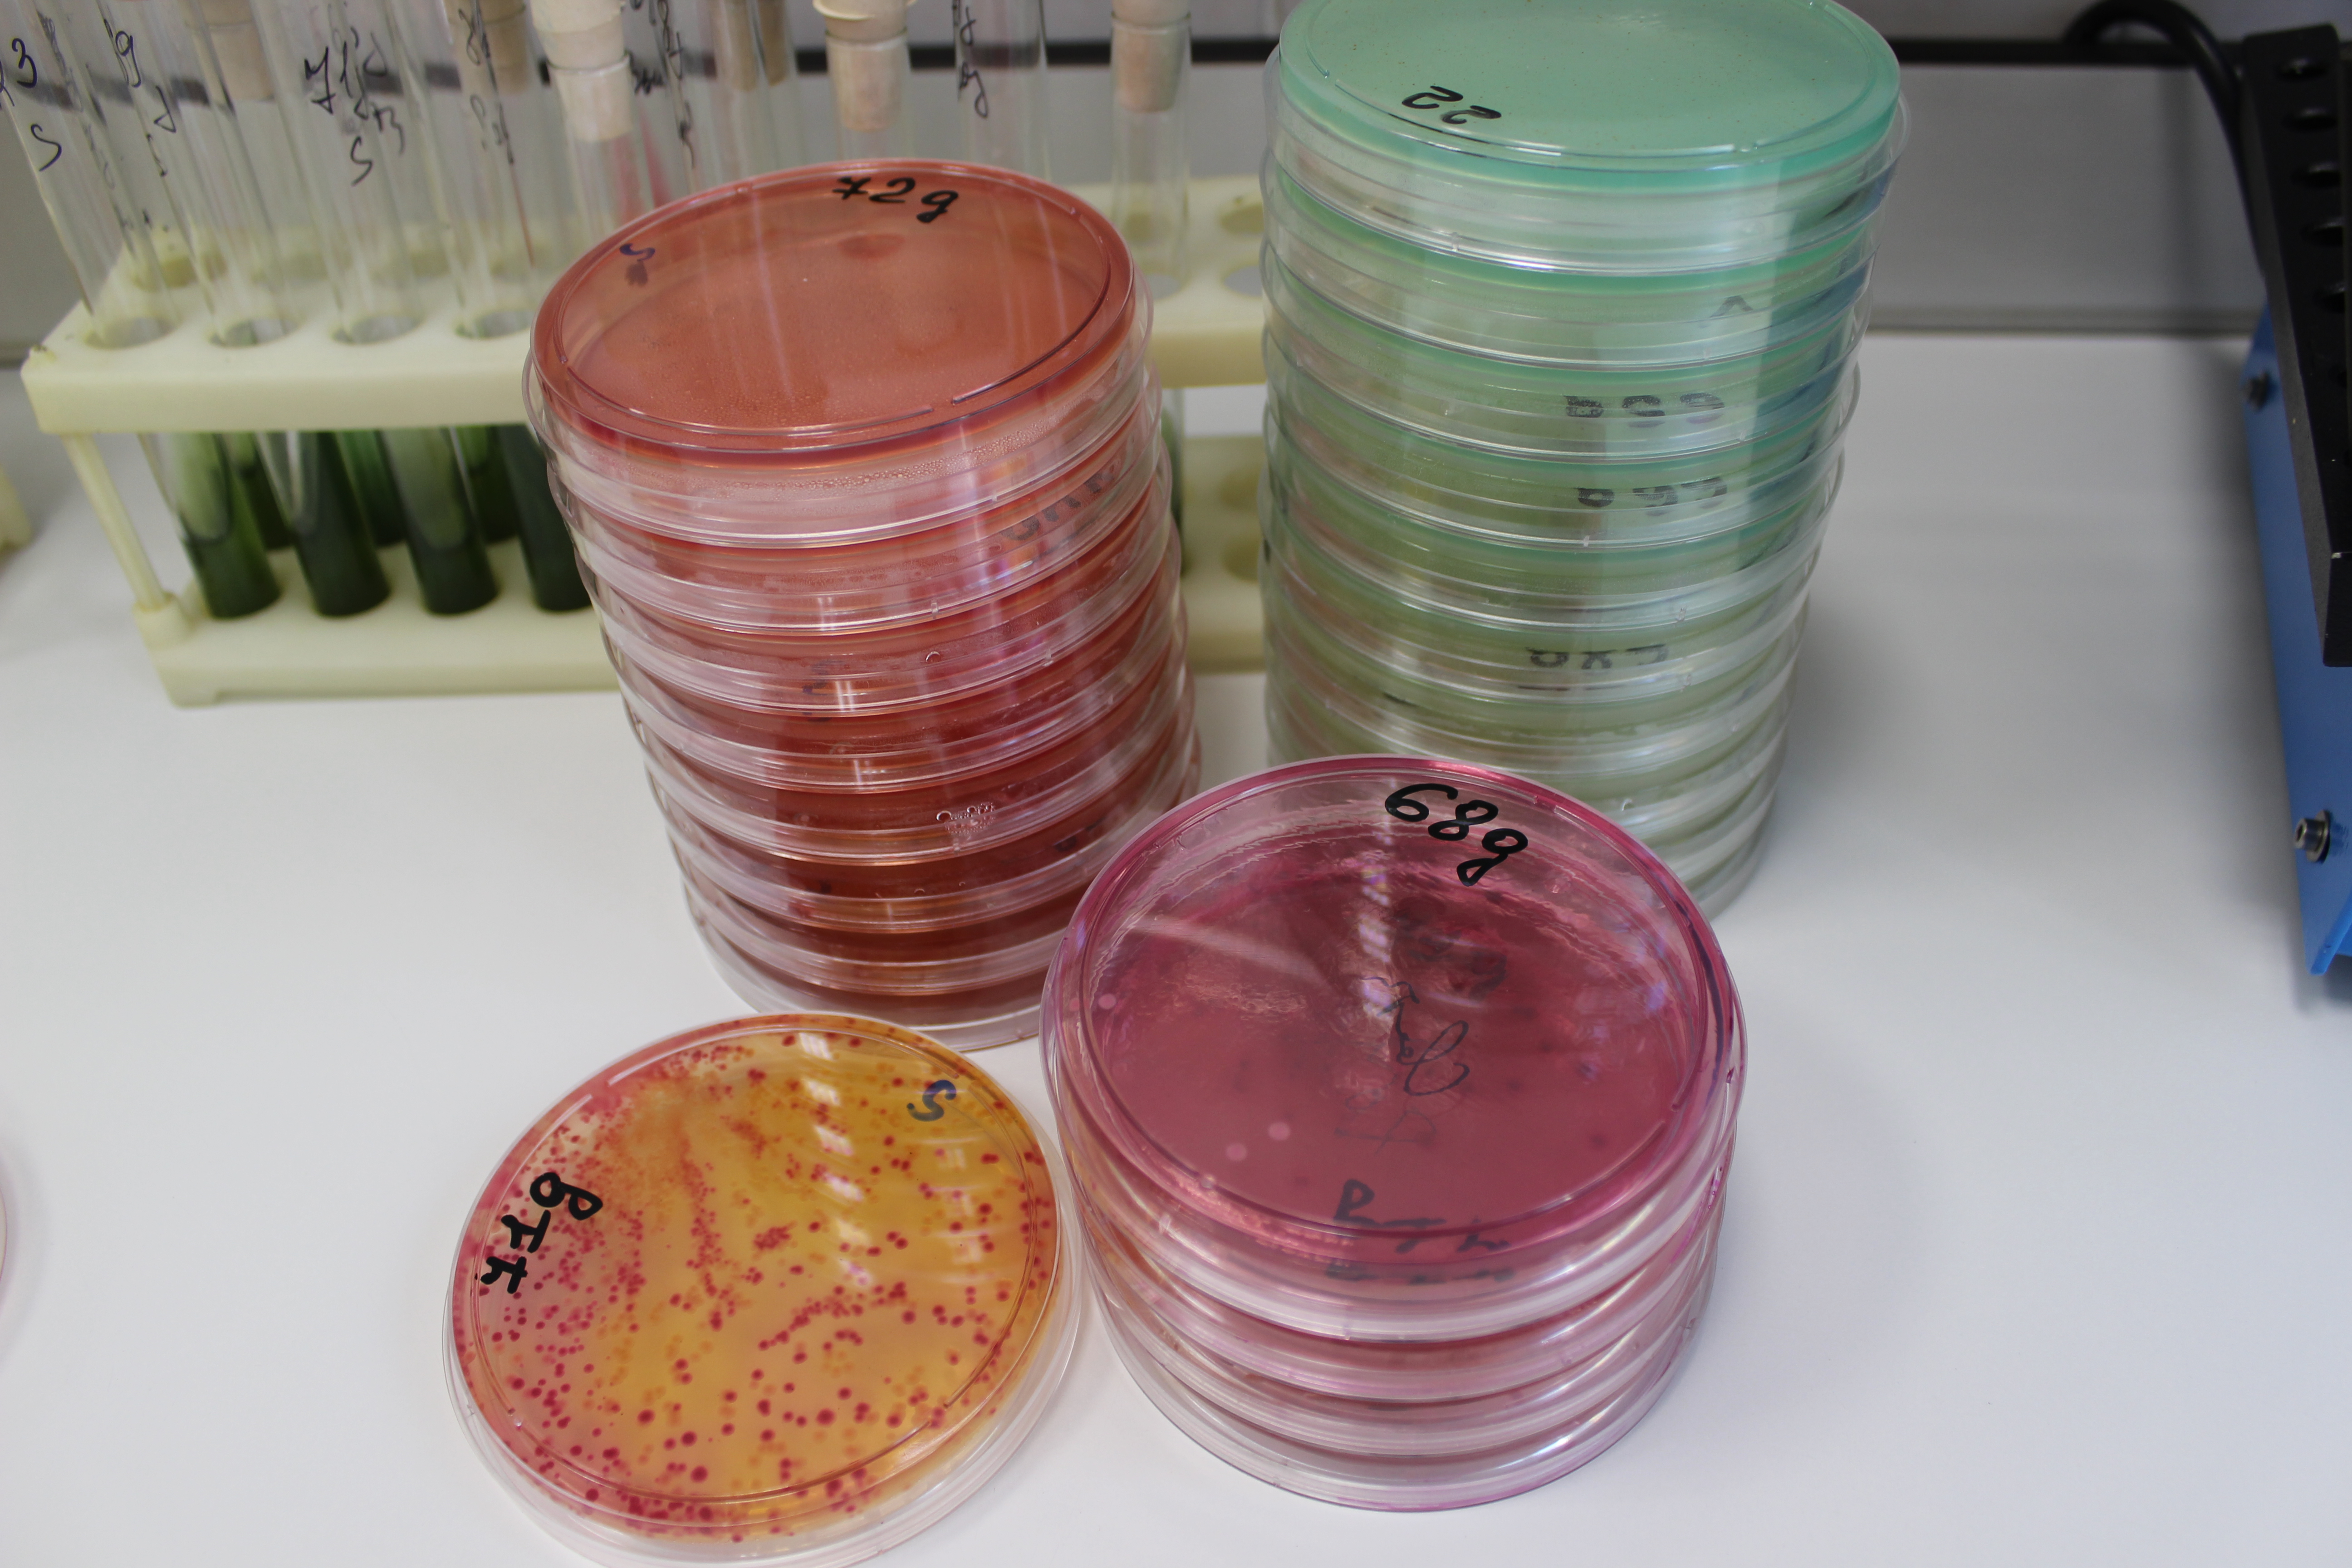
Свободный эстриол при беременности
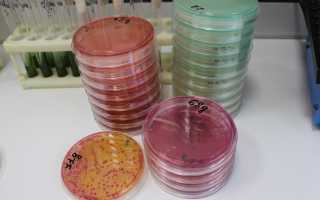
О чем свидетельствует свободный эстриол при беременности

Кто управляет беременностью
Существует мнение, что гормоны играют ключевую роль в управлении беременностью. Однако современные специалисты утверждают, что процессом на самом деле руководит ребенок, который через гормоны сообщает матери о своих потребностях.
При оплодотворении уровень эстрогена резко возрастает, сигнализируя о начале беременности. В ответ организм матери начинает активно вырабатывать прогестерон для подготовки слизистой матки к имплантации, пока оплодотворенная яйцеклетка движется по маточным трубам.
После успешной имплантации эмбриону требуется защита и питание. Он начинает вырабатывать гормон ХГЧ, который:
- Уведомляет яичники о прекращении овуляции и менструации;
- Защищает плод от иммунной системы матери;
- Предотвращает распад желтого тела, обеспечивая постоянную выработку прогестерона для подготовки матки к вынашиванию.
Этот механизм лежит в основе процесса. Если ребенку требуется больше энергии для роста, плацента начинает вырабатывать гормон HPL. Для подготовки груди к кормлению гипофиз вырабатывает пролактин, а по завершении развития ребенка активируется окситоцин, отвечающий за родовую деятельность.
Свободный эстриол является важным маркером, который врачи используют для оценки состояния беременности. Уровень этого гормона начинает повышаться с первых недель и достигает максимума к третьему триместру. Врачи отмечают, что низкие уровни свободного эстриола могут свидетельствовать о возможных проблемах с плацентой или о задержке в развитии плода. В то же время, повышенные значения могут указывать на многоплодную беременность или другие особенности, требующие внимания. Регулярный мониторинг уровня свободного эстриола помогает врачам своевременно выявлять риски и принимать необходимые меры для обеспечения здоровья матери и ребенка. Таким образом, анализ свободного эстриола становится важным инструментом в ведении беременности.

Гормоны в качестве диагностики и мониторинга
Гормоны играют ключевую роль в беременности и служат индикаторами, помогающими определить развитие ситуации и оценить здоровье матери и ребенка.
| Уровень свободного эстриола в моче/плазме | Вероятное состояние плода/плаценты | Дополнительные исследования/замечания |
|---|---|---|
| Нормальный уровень | Нормальное развитие плода и плаценты | Регулярное наблюдение |
| Пониженный уровень | Задержка внутриутробного развития (ЗВУР), фетоплацентарная недостаточность, хромосомные аномалии плода, угроза прерывания беременности, гипоксия плода | УЗИ, КТГ, допплерометрия, анализ крови на другие гормоны |
| Повышенный уровень | Многоплодная беременность, гестоз, сахарный диабет у матери | Уточнение диагноза, мониторинг состояния матери и плода |
Основные гормональные обследования при беременности
Первым тестом является анализ на хорионический гонадотропин (ХГЧ). Он подтверждает беременность и отслеживает развитие плода в первом триместре.
При нормальной беременности уровень ХГЧ удваивается каждые 48 часов. Когда плацента начинает функционировать, потребность в гонадотропине снижается, и его концентрация уменьшается. Если в первые 12 недель уровень ХГЧ не растет, это может указывать на внематочную беременность или риск выкидыша. Высокие значения ХГЧ могут свидетельствовать о многоплодной беременности.
На более поздних сроках, особенно у женщин с повышенным риском, дополнительно контролируют уровень свободного эстриола в плазме крови матери.
Свободный эстриол — это один из ключевых гормонов, уровень которого активно исследуется во время беременности. Многие женщины, ожидая малыша, интересуются, что именно говорит этот показатель о состоянии их здоровья и развитии плода. Высокий уровень свободного эстриола может свидетельствовать о нормальном развитии плаценты и плода, а также о том, что организм успешно справляется с гормональными изменениями. В то же время, низкие значения могут насторожить врачей, так как это может указывать на возможные проблемы, такие как задержка в развитии плода или риск выкидыша. Поэтому регулярный мониторинг этого гормона становится важной частью пренатального контроля. Женщины часто делятся своими переживаниями и опытом, отмечая, как результаты анализов влияют на их эмоциональное состояние и уверенность в благополучном исходе беременности.

Свободный эстриол — что это
Гормон, относящийся к группе эстрогенов, является продуктом обмена эстрадиола и эстрона. Обычно он имеет низкую биологическую активность. Вырабатывается в яичниках и служит индикатором зрелости половой системы. Благодаря умеренной активности, он используется как медикамент для контроля симптомов менопаузы, не увеличивая эндометрий.
С началом беременности уровень этого гормона резко возрастает, а после первого триместра его заменяет гонадотропин, который важен для успешного протекания беременности. Он синтезируется плацентой и надпочечниками плода, а часть необходимых веществ поступает от печени матери.
Функции гормона:
- Обеспечивает качество кровообращения в фетоплацентарной системе;
- Уменьшает сопротивляемость сосудов, способствуя нормальной циркуляции крови;
- Способствует развитию молочных желез, участвуя в формировании протоковой системы.
Нормальные уровни свободного или неконъюгированного эстриола Е3 указывают на целостность фетоплацентарного комплекса, состоящего из матери, плаценты и плода. Динамика изменения концентрации этого гормона позволяет оценить:
- Исполнение функций плаценты;
- Развитие плода;
- Способность организма матери справляться с нагрузками беременности.
Свободный эстриол при беременности — норма
Уровень гормона начинает значительно увеличиваться после 12 недели беременности. С момента имплантации 90% эстрогена в моче беременной женщины составляет эстриол. Однако многие лаборатории измеряют общий уровень эстрогена, а не конкретно эстриол.
Для определения уровня свободного эстриола во время беременности используют сыворотку крови, а не мочу, из-за более узкого диапазона значений. Обычно измерение производится в нг/мл, хотя иногда нормы могут быть представлены в нмоль/л.
| Срок беременности по неделям | Норма свободного эстриола в нг/мл |
| 16 до 20 недель | 1,0 до 3,5 нг/мл |
| От 20 до 24 недель | от 2,0 до 8,0 нг/мл |
| 24 до 28 недель | 3,0 до 9,0 нг/мл |
| 28 до 32 недель | от 4,0 до 10,0 нг/мл |
| 32 до 36 недель | 4,0 до 20,0 нг/мл |
| 36 до 38 недель | 10,0 до 32,0 нг/мл |
| 39 до 40 недель | от 9,0 до 30,0 нг/мл |
Повышенные уровни гормона могут указывать на:
- Многоплодную беременность.
- Увеличение уровня окситоцина, связанное с началом родов.
Пониженные уровни гормона могут свидетельствовать о:
- Недостаточности плаценты при здоровом плоде;
- Замедленном росте, гипоксии или гибели плода;
- Врожденной гиперплазии надпочечников у ребенка;
- Анэнцефалии;
- Врожденных хромосомных аномалиях, таких как трисомия и синдром Дауна;
- Конфликте по резус-фактору и группе крови.
Низкий уровень свободного эстриола у матери может указывать на:
- Тяжелую анемию;
- Заболевания печени;
- Сахарный диабет;
- Возможную связь с этнической принадлежностью матери.

В каких ситуациях результаты анализов не учитываются
Анализ не будет надежным, если у матери есть заболевания почек или она принимает:
- Пенициллин;
- Кортикостероиды;
- Бетаметазон;
- Диуретики;
- Эстрогены;
- Фенолфталеин.
В этих случаях результаты окажутся недостоверными.
Роль свободного эстриола при проведении скрининговых тестов
Определение уровней гормонов в зависимости от срока беременности используется в скрининговых тестах тройного и четверного экранов. Эти тесты оценивают вероятность врожденных и хромосомных аномалий у ребенка, но не являются диагностическими. Скрининг тройного экрана проводится с 15 по 17 недели беременности и включает анализ крови матери на содержание:
- Хорионического гонадотропина;
- Сывороточного альфа-фетопротеина (AFP) — важного маркера для диагностики амниотической жидкости и врожденных аномалий, таких как расщелина нервной трубки;
- Свободного эстриола.
Низкие уровни AFP и неконъюгированного эстриола при высоких значениях ХГЧ могут указывать на риск синдрома Дауна.
Скрининг позволяет предсказать до 68% случаев синдрома Дауна, но не является диагностическим. Результаты представляются в виде вероятностной аналитики, например, 1:200, что означает, что из 200 женщин с аналогичными результатами, 1 может иметь ребенка с синдромом Дауна или врожденными аномалиями; нормой считается 1:270.
Если результаты теста неблагоприятные, через неделю рекомендуется повторное исследование и дополнительные анализы для подтверждения или опровержения диагноза.
Кто должен пройти исследование на уровень свободного эстриола:
- Женщины старше 35 лет, особенно при первой беременности;
- Беременные с мужчинами старше 45 лет;
- Женщины с гипертонией или сахарным диабетом;
- При подозрении на преэклампсию;
- В случае тяжелых токсикозов во втором и третьем триместре, особенно с отеками, повышенным давлением, головными болями и спутанностью сознания.
Также основанием для исследования могут быть:
- Врожденные аномалии у предыдущих детей;
- Неблагоприятная семейная история;
- Подозрение на недостаточность плаценты, ее преждевременное отслоение и маточные кровотечения.
Это важно
Результаты анализа следует оценивать в динамике, так как отдельный тест не имеет диагностической ценности и не должен вызывать беспокойства. При неудовлетворительном результате назначается повторное исследование. Только если уровни свободного эстриола остаются низкими на протяжении всей беременности и не наблюдаются изменения, можно с уверенностью говорить о наличии внутриутробной задержки развития плода.
Можно ли изменить результаты анализов в нужную сторону
Если мы хотим восстановить уровень свободного эстриола, нужно выявить и устранить причину его низких показателей. Искусственное увеличение этого гормона не нормализует работу плаценты и не предотвратит врожденные аномалии. Важно определить, например, дисфункцию плаценты, и при необходимости медикаментозно устранить это состояние. После лечения уровень свободного эстриола может вернуться к норме.
Плохие результаты анализов не должны вызывать панику. Это возможность вовремя выявить и решить проблему, что может помочь спасти ребенка, сохранить беременность или, в некоторых случаях, принять решение о ее прерывании, чтобы избежать рождения с серьезными хромосомными аномалиями. Все зависит от нас.
Вопрос-ответ
Что такое эстриол свободный при беременности?
E3 – стероид, женский половой гормон. Обладает существенно меньшей биологической активностью, чем другие женские половые гормоны: эстрадиол и эстрон. Вне беременности E3 образуется при трансформации эстрона в периферических тканях; его концентрация в крови низкая.
Что показывает анализ на свободный эстриол?
Анализ крови на эстрадиол, эстрон и эстриол — это исследование, которое помогает оценить уровни основных женских половых гормонов. Эти гормоны играют важную роль в репродуктивной системе и общем здоровье.
Что означает пониженный уровень эстриола во время беременности?
Пониженный уровень эстриола бывает при: фето-плацентарной недостаточности, угрозе прерывания беременности или преждевременных родов, пузырном заносе, переношенной беременности.
Советы
СОВЕТ №1
Обратите внимание на уровень свободного эстриола в крови. Этот гормон может служить индикатором здоровья плода и состояния беременности. Регулярные анализы помогут вам отслеживать изменения и вовремя реагировать на возможные отклонения.
СОВЕТ №2
Консультируйтесь с вашим врачом о значении результатов анализов. Понимание того, что именно означает уровень свободного эстриола, поможет вам лучше ориентироваться в процессе беременности и принимать обоснованные решения.
СОВЕТ №3
Не забывайте о важности комплексного подхода к беременности. Уровень свободного эстриола — это лишь один из показателей. Следите за общим состоянием здоровья, правильно питайтесь и регулярно проходите обследования.
СОВЕТ №4
Если у вас есть опасения или вопросы по поводу уровня свободного эстриола, не стесняйтесь задавать их своему врачу. Открытое общение поможет вам чувствовать себя увереннее и спокойнее в течение всей беременности.